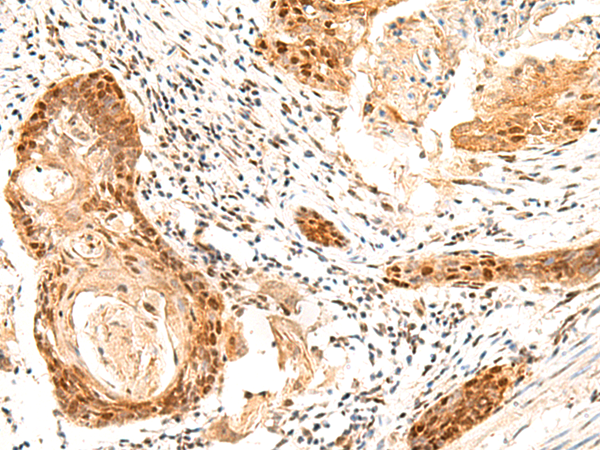

-
分类: 科研抗体货号: P10115别名: Mar1; METNASE应用: IHC反应种属: Human, Mouse
-
分类: 科研抗体货号: P10125别名: GMD; SDR3E1应用: IHC反应种属: Human, Mouse
-
分类: 科研抗体货号: P10114别名: IFRX; IRXL1; C10orf48应用: IHC反应种属: Human, Mouse
-
分类: 科研抗体货号: P10131别名: MES; MKS; BBS13; POC12; JBTS28应用: WB,IHC反应种属: Human, Mouse, Rat
-
分类: 科研抗体货号: P10124别名: ERT; ESX; EPR-1; ESE-1应用: IHC反应种属: Human
-
分类: 科研抗体货号: P10140别名: FAM46C应用: IHC反应种属: Human, Mouse, Rat
-
分类: 科研抗体货号: P10130别名: NLI; CLIM2; LDB-1; CLIM-2应用: IHC反应种属: Human, Mouse
-
分类: 科研抗体货号: P10123别名: DS; DHS; MIG13应用: WB,IHC反应种属: Human, Mouse, Rat
-
分类: 科研抗体货号: P10139别名: PDHA; PDHAD; PHE1A; PDHCE1A应用: WB,IHC反应种属: Human, Mouse, Rat
-
分类: 科研抗体货号: P10129别名: CT10; HCA587; MAGEE1应用: WB,IHC反应种属: Human

鄂公网安备42018502007531号
鄂公网安备42018502007531号

